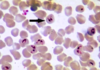

Efecto adverso más frecuente de la daptomicina?
Incremento CPK
Antipseudomónicos
Para MAChACar Las CInCo pseudos ( 10 )
Pipertazo
Meropenem
Aztreonam
Cefepime
Aminoglu
Ceftazidima
Levofloxacino
Colistina
Imipenem
Cipro
Con qué se relaciona las becteriemias por S.bovis
Neoplasias intestino
Tto elección E.faecalis
Ampicilina
Qué mo tienen como tto elección la ampicilina?
Listeria
E. Faecalis
ATB CI en la gestación
Aminoglucósidos
Tetraciclinas
Quinolonas
Unicos ATB VO que cubren Pseudomona aeruginosa?
Quinolonas
Efectos adversos quinolonas
Gastrointestinales, neurológicos y musculoesqueléticos
Rotura tendón aquiles
Quinolona anaerobia
Moxifloxacino
Quinolonas respiratórias
3a i 4a:
Levofloxacino i moxifloxacino
ATB de elección en bacterias intracelulares
TQM
Tetraciclinas
Quinolonas
Macrolidos
Efecto adverso tetraciclinas
Fototoxicidad ( doxiciclina ) , discoloración dientes y huesos en niños
tto Toxoplasmosis
Sulfadiazina-pirimetamina
Único ATB frente MARSA que se puede administrar VO
Linezolid
Efecto adverso Linezolid
Mielosupresión ( trombocitopenia )
Qué inactiva a la daptomicina?
Sulfactante pulmonar - Nunca usar neumonías
En qué bacterias GN no actua la tigeciclina?
Pseudomona
Proteus
Providencia
Con qué farmaco se produce el efecto disulfiram con el OH?
Metronidazol
ATB anaerobis
Carbapenem
Metronidazol
Clindamicina
Amoxiclav
Ampisulbac
Pipertazo
Cefoxitina
Moxifloxacino
Cloramfenicol
Tiglicilina
Mo relacionado con patologia del colon
S. Gallolyticus
Efecto adverso Vancomicina
Sd hombre rojo
Aminoglucosidos
La GENTe AMIga NEOnazi ESToRBA
Gentamicina
Amikacina
Neomicina
Estreptomicina
Tobramicina
Macrólidos
ERIc AZota a CLARa
Eritromicina
Azitromicina
Claritromicina
Bacterias cubre cotrimoxazol
Nocardia
Pneumocistis jiro
Strenotrophomona maltophila